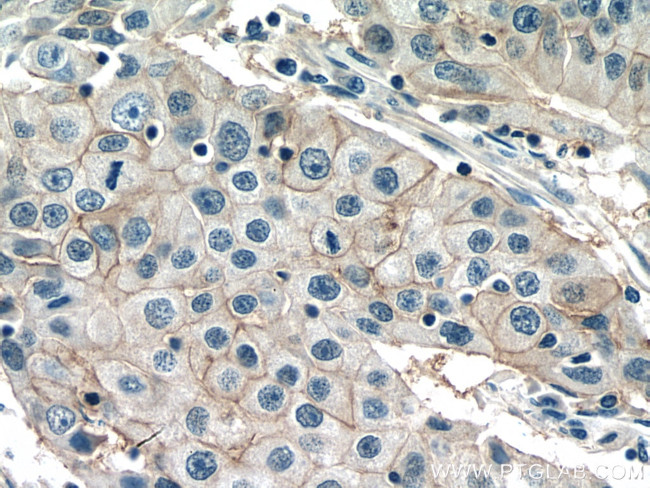
NAT2 Antibody in Immunohistochemistry (Paraffin) (IHC (P))

Search
Proteintech
NAT2 Polyclonal Antibody
{{$productOrderCtrl.translations['antibody.pdp.commerceCard.promotion.promotions']}}
{{$productOrderCtrl.translations['antibody.pdp.commerceCard.promotion.viewpromo']}}
{{$productOrderCtrl.translations['antibody.pdp.commerceCard.promotion.promocode']}}: {{promo.promoCode}} {{promo.promoTitle}} {{promo.promoDescription}}. {{$productOrderCtrl.translations['antibody.pdp.commerceCard.promotion.learnmore']}}
产品信息
11410-1-AP
种属反应
宿主/亚型
分类
类型
抗原
偶联物
形式
浓度
规格
纯化类型
保存液
内含物
保存条件
运输条件
产品详细信息
Immunogen sequence: MDIEAYFERI GYKNSRNKLD LETLTDILEH QIRAVPFENL NMHCGQAMEL GLEAIFDHIV RRNRGGWCLQ VNQLLYWALT TIGFQTTMLG GYFYIPPVNK YSTGMVHLLL QVTIDGRNYI VDAGSGSSSQ MWQPLELISG KDQPQVPCIF CLTEERGIWY LDQIRREQYI TNKEFLNSHL LPKKKHQKIY LFTLEPQTIE DFESMNTYLQ TSPTSSFITT SFCSLQTPEG VYCLVGFILT YRKFNYKDNT DLVEFKTLTE EEVEEVLKNI FKISLGRNLV PKPGDGSLTI
靶标信息
Participates in the detoxification of a plethora of hydrazine and arylamine drugs. Catalyzes the N- or O-acetylation of various arylamine and heterocyclic amine substrates and is able to bioactivate several known carcinogens.
仅用于科研。不用于诊断过程。未经明确授权不得转售。
篇参考文献 (0)
生物信息学
蛋白别名: Arylamide acetylase 2; Arylamine N-acetyltransferase 2; AT-2; N-acetyl transferase 2; N-acetyltransferase 2 (arylamine N-acetyltransferase); N-acetyltransferase type 2; N-Acetyltransferase-2 (arylamine N-acetyltransferase); N-hydroxyarylamine O-acetyltransferase; NAT-2; NAT2; PNAT; Polymorphic arylamine N-acetyltransferase
基因别名: AAC2; AV377607; NAT-2; NAT2; Nat2a; PNAT
UniProt ID: (Human) P11245, (Mouse) P50295, (Rat) P50298
Entrez Gene ID: (Human) 10, (Mouse) 17961, (Rat) 116632